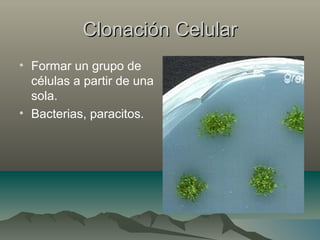
Clonación CelularClonación Celular
• Formar un grupo de
células a partir de una
sola.
• Bacterias, paracitos.

Este documento proporciona definiciones y explicaciones sobre varios temas relacionados con la clonación. Explica que la clonación es la reproducción asexual de organismos genéticamente idénticos, ya sea de forma natural o artificial. Describe los dos métodos principales de clonación, así como los tipos de clonación como la molecular, celular, de organismos de forma natural y artificial. También discute brevemente sobre Dolly, la primera oveja clonada, y los pros y contras de la clonación.